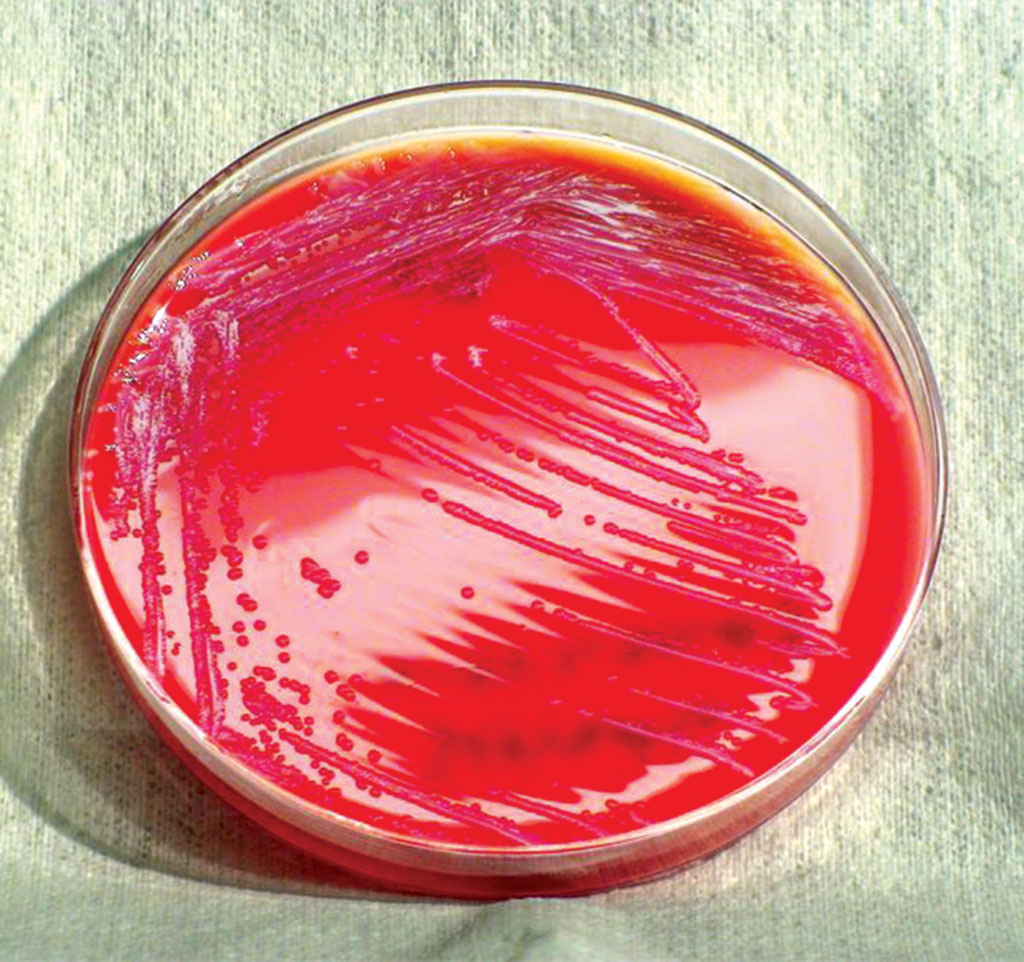
Pasieka nr 87 (bakteria_seratia)

Odkryto bakterię, która może zabijać pszczoły
Profesor Uniwersytetu w Wisconsin-Stout wraz ze swoimi podopiecznymi studentami dokonali ważnego odkrycia, mogącego określić przyczyny wymierania pszczół w czasie zimy w północnych Stanach Zjednoczonych (Upper Midwest). Profesor biologii Jim Burritt wraz ze studentami opublikowali badania nad najnowszym szczepem bakterii Serratia marcescens. Odnotowano jej zabójczą siłę, stąd zespół badawczy nadał odmianie nazwę sicaria, co znaczy „morderca”. W badaniach posługiwano się skrótem Ss1.

wiz.© Roman Dudzik
Warto przybliżyć Czytelnikom pewne cechy tego patogenu. Serratia marcescens zwana jest też pałeczką krwawą lub pałeczką cudowną. Należy do rodziny Enterobacteriaceae. W cechy biologiczne wpisuje się jej urzęsiona, bezotoczkowa budowa komórkowa.
Bakteria jest nieprzetrwalnikująca, gram-ujemna, względnie beztlenowa. Posiada zdolność do ruchu przy pomocy wici. Zakres temperatur potrzebnych do procesów życiowych kształtuje się w przedziale 10-36ºC, przy pH 5-9. W technice laboratoryjnej istotny w rozpoznaniu gatunku jest fakt, że wytwarza enzym katalazę i fermentuje glukozę.
Charakterystyczną cechą wyróżniającą te pałeczki od innych Enterobacteriaceae jest wytwarzanie 3 enzymów hydrolitycznych – DNA-zy, żelatynazy i lipazy.
Chętnie wytwarza kolonie na skrobi zawartej w pieczywie. Syntetyzuje czerwony pigment zwany prodigiozyną, który mógł być przyczyną niektórych, domniemanych cudów eucharystycznych, w czasie których na przeistoczonej hostii pojawiały się plamy krwi.
Serratia marcescens na szalce petriego.
fot.© CDC, Amanda Moore, Todd Parker, Audra Marsh
Bakteria ta jest patogenna zwłaszcza dla osób z upośledzoną odpornością. Wchodzi niekiedy w skład mikroflory przewodu pokarmowego człowieka. Jest przyczyną trudnych do wyleczenia infekcji dróg moczowych i ciężko gojących się ran.
Serratia marcescens może powodować ostre zapalenie spojówek. Często bywa przyczyną zakażeń szpitalnych. Grupą szczególnego ryzyka są pacjenci z chorobami nowotworowymi, u których może nastąpić zapalenie płuc, posocznica bakteryjna lub bakteryjne zapalenie opon mózgowo-rdzeniowych.
Powoduje też biegunkę u dzieci. Większość szczepów wykazuje oporność na całą gamę antybiotyków makrolidowych i beta-laktamów.
Profesor Burritt, który również prowadzi swoją pasiekę, twierdzi, że jego wyniki wskazują na to, że Ss1 może przyczyniać się do upadku kolonii pszczelich w czasie zimy. Duża liczba pszczelarzy na tym terenie traci ponad połowę uli każdej zimy.
W hrabstwie Dunn County, ilość upadków w czasie zimowli sięga od kilku lat aż 80%.
Bakterie są widoczne pod mikroskopem świetlnym w rozmazie hemolimfy pozyskanej od chorych pszczół z Dunn County. Pracownicy naukowi zajmujący się genetyką bakterii i biochemią na Uniwersytecie w Wisconsin-Madison użyli spektrometrii masowej i trzech niezależnych genomowych metod, by stwierdzić, że patogen ten nie był poprzednio opisywany w literaturze.
Z dużym prawdopodobieństwem można powiedzieć, że jest to nowa choroba w pszczelarstwie. UW-Stout prowadził poszukiwania pszczelarzy w 8 zachodnio–centralnych powiatach Wisconsin i wschodnich Minnesota. Do uniwersytetu dostarczono 91 próbek ulowych do przebadania wraz z raportami.
Burritt i jego studenci przebadali 3219 pszczół miodnych a przy okazji 1259 roztoczy Varroa destructor, znalezionych w ulach pomiędzy grudniem 2014 a wrześniem 2016. Ss1 został znaleziony w pszczołach i roztoczach z każdego zebranego hrabstwa.
Infekcja pszczół wywołana przez Ss1 jest powiązana ze zredukowaną liczbą hemocytów obronnych w organizmie pszczół, wskutek czego dochodzi do sepsy, a potem następuje śmierć owada. Badania dowodzą, że infekcja może skracać życie pszczół.
.jpg)
fot.© Milan Motyka
Użyto trzech kryteriów identyfikujących próbki z grupy żyjących pszczół:
Badanie, w którym studenci Anna Winfield i Jake Hildebrand byli współautorami, opublikowano 21 grudnia w PLOS One, z wolnym dostępem online „Sepsis and Hemocyte Loss in Honey Bees”.
Piotr Nowotnik
Bibliografia:
- [Internet 1]: http://journals.plos.org/plosone/article?id=10.1371/journal.pone.0167752
- [Internet 2]: http://www.uwstout.edu/news/articles/Professor-students-identify-bacterium-that-may-kill-honey-bees.cfm
- [Literatura 1]: Wybrane zagadnienia z mikrobiologii żywności, S. Błażejak, I. Gientka, Wydawnictwo SGGW, Warszawa 2010
<?php $pas="2018nr1str30"; $pasCov="images/stories/Pasieka/2018_1/Pasieka_2018nr01_[87].jpg"; include("./goto/art_footer.php"); ?>



